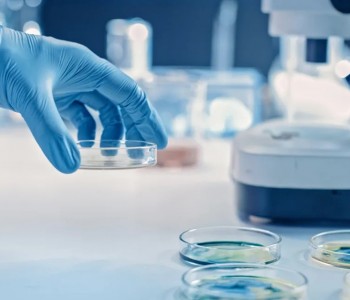

Блог amv212
всего записей -
3368
Блог amv212
всего записей -
3368
всего записей -
3368
Новые капсулы с наночастицами помогут пробиотическим микроорганизмам победить заболевания кишечника
Ученые покрыли бактерий слоем защитного биоматериала и экипировали "рюкзаками" с лекарственными молекулами
Основатель FTX обанкротил биржу, чтобы обеспечить победу демпартии США на промежуточных выборах
Скандал с банкротством FTX, победой демократической партии США , Украиной и пожертвованиями на борьбу с Россией. Сэм Бланкман-Фрид, основатель FTX, второй после Сороса донор демократов на промежуточных выборах
Компания набрала заказов на $2 млрд для производства "тормозной системы будущего" к 2025 году
Немецкая технологическая компания Continental Automotive утверждает, что в третьем квартале получила первый крупный заказ на свою полусухую тормозную систему под названием Future Brake System (FBS).
Военный космический беспилотник США на солнечных батареях благополучно приземлился спустя 908 дней
За 3 774 дня пребывания на орбите военный аппарат X-37B, работающий на солнечной энергии, преодолел более 2 млрд километров
Ученым впервые удалось заснять разъяренных осьминогов, бросающих друг в друга камни
Подобное поведение у осьминогов никогда ранее не наблюдалось
Ученые: В квантовом мире свет может одновременно двигаться вперед и назад во времени
Пока все это очень сложно для понимания, но очень, очень интересно, заявили исследователи
Зеленский заявил, что не может быть эффективной климатической политики без мира во всём мире
"Возможно, удастся сохранить мир без успешной адаптации к климату, но успешная адаптация к климату невозможна в отсутствие мира"
Генетически модифицированная лиана очищает воздух в помещении в 30 раз эффективнее обычных растений
Молодая французская компания четыре года работала над созданием генетически модифицированной лианы эпипремнума золотистого. Сегодня биотехнология Neo P1 улавливает формальдегид, бензол, толуол и ксилол в 30 раз эффективнее, чем природный аналог.
Сконструированные бактерии, управляемые магнитом, успешно уничтожили неоперабельный рак
Для того чтобы доставить бактерий, способных уничтожить рак, к неоперабельным опухолям, исследователи использовали магнитное поле. Конечный результат - высокоэффективная терапия.
Учёные превратили яичный белок в дешевое средство для эффективной очистки воды
Яичный белок может быть превращен в материал, способный эффективно удалять соль и частицы микропластика из морской воды
Из мицелия гриба создали биоразлагаемый чип, который можно скручивать, сгибать и нагревать до 200°C
Подложка для компьютерных чипов и аккумуляторов, как правило, изготавливается из неперерабатываемого пластика, но использование вместо него мицелия трутовика позволит сократить количество электронных отходов
Как поиски секретных испытаний ядерного оружия привели к открытию самых мощных взрывов во Вселенной
Взрывающиеся звезды выбрасывают чрезвычайно мощные всплески электромагнитного излучения. Изучая их, мы можем узнать больше о звездной эволюции и строении космоса.
Байден на климатическом саммите COP27 призвал лидеров стран бороться за справедливый мир
В целом, переговорный процесс на саммите зашел в тупик. Особую озабоченность вызывают призывы США к удвоению финансирования для сокращения выбросов углекислого газа
Илон Маск сообщил сотрудникам Twitter о возможном банкротстве компании
Сократив половину сотрудников Twitter, Илон Маск подтолкнул топ-менеджеров к увольнению, угрожая банкротством компании. Интересно выживет ли социальная сеть в условиях нового кризиса?
В водах Атлантики найден фрагмент космического шаттла "Челленджер", взорвавшегося в 1986 году
Водолазы нашли в Атлантике фрагмент космического корабля "Челленджер" спустя почти 37 лет после катастрофы
Тегеран объявил о создании первой иранской гиперзвуковой баллистической ракеты
Командующий аэрокосмическими силами Корпуса стражей исламской революции заявил, что КСИР Ирана успешно провел испытания гиперзвуковой баллистической ракеты отечественного производства.
Установлен новый рекорд скорости передачи данных по стандартному оптическому волокну в 1,53 Pbit/s
Физики установили рекорд скорости передачи данных в 1,53 петабита в секунду в 55-модовом оптоволокне со стандартным диаметром оболочки
Норвежские учёные предложили новый метод лечения инсульта
Новый метод лечения инсульта пока находится в стадии доклинических экспериментов и пока не прошел испытания на людях.
В Австралии одобрен первый в мире препарат, разработанный на базе микробиома донора
Биотехнологическая компания BiomeBank объявила о первом в мире нормативном одобрении препарата, разработанного на основе микробиома донора. Новое лекарство эффективно устраняет симптомы опасных кишечных заболеваний
Объявление Tesla о найме сотрудников на Cybertruck может свидетельствовать о начале производства
Возможно, это сигнализирует о запуске автомобиля в серийное производство.